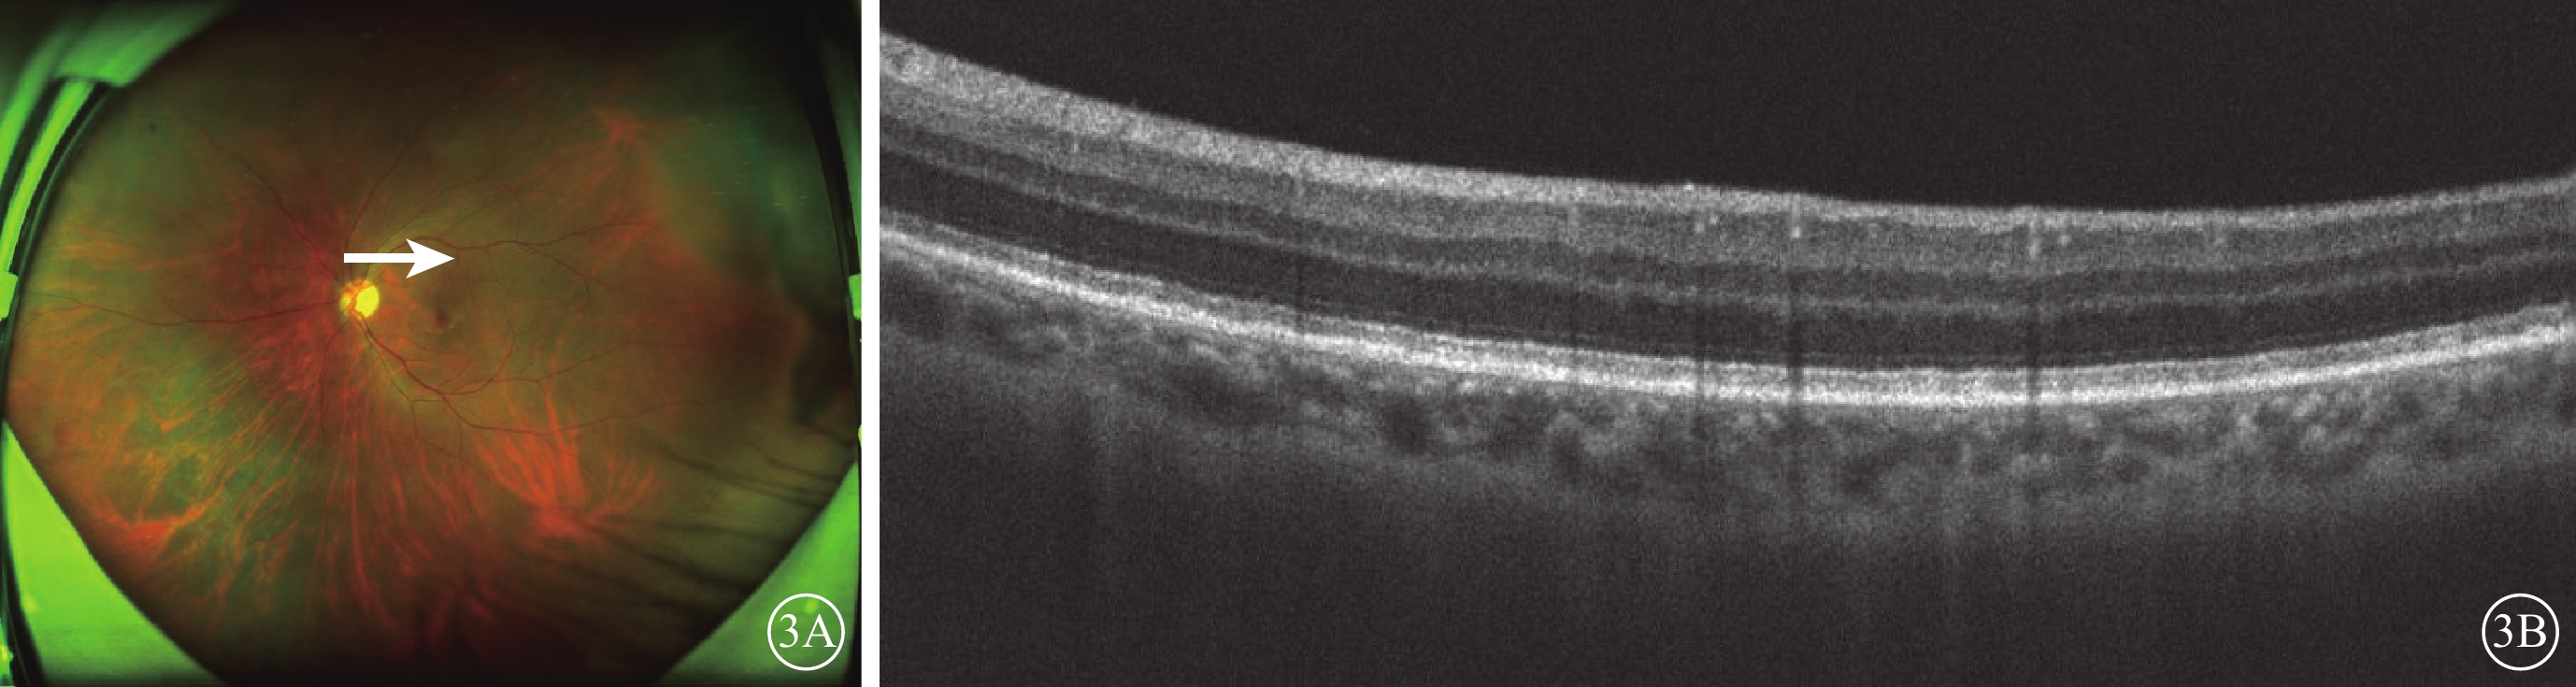

引用本文: 朱婕, 李喆, 徐敏, 李姍姍, 陳放. 原發于中樞神經系統淋巴瘤的眼內淋巴瘤1例. 中華眼底病雜志, 2022, 38(7): 601-603. doi: 10.3760/cma.j.cn511434-20210824-00458 復制
患者男,50歲。因右眼視物不見5個月伴眼痛10 d,于2019年10月2日就診于揚州大學附屬蘇北人民醫院眼科。患者于2018年5月在我院血液科確診為原發于中樞神經系統的彌漫性大B細胞淋巴瘤,經多次化學藥物治療(化療),自訴目前病情穩定。眼部檢查:右眼最佳矯正視力(BCVA)光感,左眼BCVA 1.0。右眼、左眼眼壓分別為22、13 mm Hg(1 mm Hg=0.133 kPa)。右眼角膜清,前房細胞(++),晶狀體輕度混濁,玻璃體混濁明顯;左眼眼前節未見明顯異常。眼底檢查,右眼隱約見后極部及顳側視網膜大片黃白色病灶及出血灶,呈“奶酪番茄醬樣”改變(圖1A);左眼黃斑區黃色環形病灶(圖1B)。光相干斷層掃描(OCT)檢查,左眼黃斑中心凹顳側小片視網膜色素上皮(RPE)隆起(圖1C)。熒光素眼底血管造影(FFA)檢查,右眼視網膜動靜脈管壁均有熒光素著染,周邊視網膜大片無灌注區(圖1D);左眼黃斑區多個點狀強熒光。雙眼房水檢測,右眼巨細胞病毒(CMV)免疫球蛋白(IgG)值86.15 U/ml(參考值范圍<9 U/ml),但CMV、單純皰疹病毒、水痘-帶狀皰疹病毒、EB病毒等病毒核酸拷貝數均為0;雙眼白細胞介素(IL)-10/IL-6比值正常(參考值范圍<1.0)。我院血液科會診認為無其他臟器淋巴瘤復發表現。結合患者病史,眼科診斷:右眼CMV性視網膜炎(CMVR)。因患者病程已有5個月,試予全身靜脈滴注阿昔洛韋、右眼玻璃體腔注射更昔洛韋治療。患者自述右眼疼痛好轉,視力無變化。2個月后再次行右眼房水檢測,提示CMV-IgG濃度為13.61 U/ml,較入院時下降。2020年4月復查,患者右眼視力手動,左眼視力1.0。右眼玻璃體混濁明顯好轉,原病變區視網膜萎縮呈灰色;左眼較前無明顯變化。

2020年10月11日,患者因左眼視力下降4 d于我院復查。右眼BCVA無光感,左眼BCVA 0.6。右眼、左眼眼壓分別為14、12 mm Hg。雙眼玻璃體混濁(+)。眼底檢查,右眼視網膜可見陳舊性病灶(圖2A);左眼鼻下象限視網膜見片狀灰白色病灶,夾雜少量出血灶,顳上及后極部視網膜可見視網膜下呈簇狀分布的點狀白色病灶(圖2B)。眼底自身熒光檢查,左眼后極部視網膜呈“豹斑樣”熒光改變(圖2C);右眼全視網膜散在大量點片狀弱熒光。FFA檢查,左眼鼻下方視網膜血管壁見熒光素滲漏,后極部視網膜呈“豹斑樣”改變(圖2D,2E)。進一步OCT掃描左眼后極部白色點狀病灶處,可見RPE上下多個結節樣強反射病灶(圖2F)。左眼房水檢測,IL-10值顯著升高至248.9 pg/ml(參考值范圍0.0~5.0 pg/ml)、IL-10/IL-6比值升高至3.62,CMV等病毒的核酸拷貝數為0,IgG正常。我院血液科會診行骨髓穿刺、頭顱、腹部CT等檢查后,未發現其他臟器淋巴瘤復發表現。經多科會診,結合患者病史,診斷:原發于中樞神經系統的彌漫性大B細胞淋巴瘤左眼眼內復發,即眼內淋巴瘤(IOL)。血液科認為無需全身化療。遂給予左眼玻璃體腔注射甲氨蝶呤治療,共9次。2021年2月復查,患者全身情況穩定。左眼視力1.0;左眼鼻下及顳上視網膜病灶均明顯消退(圖3A);OCT檢查,左眼后極部視網膜強反射病灶基本消退(圖3B)。2021年9月隨訪,患者病情未復發。


討論 IOL臨床表現變化多端,無特異性。本例患者確診為原發于中樞神經系統的淋巴瘤,因長期化療導致免疫功能低下,右眼眼底表現為典型的“奶酪番茄醬樣”改變,雖然房水檢測僅提示右眼CMV-IgG增高,病毒DNA拷貝數為0,但結合患者的免疫低下狀態,雙眼IL-10/IL-6比值正常,考慮可能為右眼CMVR。經過全身和玻璃體腔抗病毒治療后,患者眼底病灶未進展,病變區視網膜逐步萎縮,復查CMV-IgG濃度降低。1年后再次就診時,患者左眼視力下降,其鼻下方視網膜有出血及黃白色病灶,FFA示左眼血管炎樣改變,結合患者病史,不能排除CMVR可能;但其左眼顳上方視網膜有簇狀分布的白點狀病灶,位于視網膜下,眼底自身熒光及FFA呈“豹斑樣”熒光改變,OCT表現為RPE上下多個結節樣強反射病灶,這些病灶又高度提示淋巴瘤細胞浸潤不除外。研究表明,OCT對IOL的診斷陽性預測值達88.9%[1],RPE層及RPE之上可觀察到增大的結節狀強反射病灶,可有Bruch膜與RPE層分離,形成與息肉樣脈絡膜血管病變類似的雙層征樣改變[2]。于是進一步行左眼房水檢測,提示IL-10/IL-6比值>1,而病毒DNA拷貝數及抗體均不高,結合患者原發性中樞神經系統淋巴瘤病史,考慮患者左眼為IOL浸潤。經左眼連續玻璃體腔注射甲氨蝶呤治療后,患者左眼視力提升,顳上方視網膜下病灶消退,鼻下方類似視網膜血管炎表現的病灶亦消退,驗證了之前的診斷。
IOL可表現為玻璃體混濁及視網膜下浸潤等[3-4],以視網膜血管炎為主要表現的報道并不多見[5]。本例患者左眼有視網膜血管炎表現,但后極部視網膜的黃白色病灶引起了我們的警惕。左眼經玻璃體腔注射甲氨蝶呤治療后病灶均明顯消退,遂考慮為淋巴瘤偽裝成視網膜血管炎而非CMVR。細胞因子分析在IOL的診斷中也存在著重要作用,在該類患者中,IL-10表達量遠超過IL-6,即IL-10/IL-6比值升高并>1[6]。但同時,IOL并不都表現出IL-10或者IL-10/IL-6比值增高,該指標僅可輔助IOL診斷[7]。如果能夠抽取該患者的玻璃體液進行細胞病理學檢查[8-9],對該患者的診斷更有幫助。在本例患者的診斷過程中,我們通過多模式影像學檢查,臨床有了初步擬診,眼內液的檢測起到了重要的輔助作用,為臨床提供了眼內局部抗原和免疫反應信息,有助于快速診斷及精準治療[10]。
56%~90%的原發性IOL患者或將出現中樞神經系統的淋巴瘤表現,而15%~25%的原發性中樞神經系統淋巴瘤患者可發生眼部淋巴瘤表現[11]。根據國際原發性中樞神經系統淋巴瘤協作小組研討會上發布的報告,IOL的診斷可通過腦組織活檢確診淋巴瘤、磁共振成像或腦脊液檢查、眼內組織細胞學或免疫組織化學檢查(IL-10/IL-6輔助)[12]。本例患者有明確的原發性中樞神經系統淋巴瘤病史,因考慮視網膜屬于視覺中樞神經系統起始處,且其他臟器未見淋巴瘤改變,與血液科會診討論,認為該患者第2次就診時左眼的眼部病變為原發于中樞神經系統的彌漫性大B細胞淋巴瘤的眼內復發,而不建議診斷為淋巴瘤眼內轉移。
目前對于IOL的治療,國際上尚無標準統一的治療方案,目前臨床常用的包括全身化療藥物的使用、局部眼球放射治療及玻璃體腔注射甲氨蝶呤[13]。甲氨蝶呤可以穿透血腦屏障及血眼屏障,其治療IOL的有效性及安全性也得到了證實,連續玻璃體腔注射甲氨蝶呤可控制IOL的發展,減少腫瘤復發的可能,甚至提高患者視力[14]。本例患者經血液科評估后,未使用全身化療,單純連續玻璃體腔注射甲氨蝶呤后,病情好轉并且穩定。目前大部分學者認為IOL雖然具有較高的放化療敏感性,但獲得的緩解也僅僅較低的短期總體生存率[15],有效控制該病的遠期復發及中樞神經系統擴散仍然面臨很大挑戰,故本例患者仍需長期隨訪觀察。
淋巴瘤患者的眼部病變變化多端,需要結合臨床表現、眼部多模式影像學檢查、免疫學檢測、細胞學檢查、分子生物學的檢測結果綜合判斷,并建立一個以眼科醫師、神經腫瘤醫師及血液腫瘤學醫師、病理學專家的多學科聯盟,以優化患者的治療方案,改善患者的預后。
患者男,50歲。因右眼視物不見5個月伴眼痛10 d,于2019年10月2日就診于揚州大學附屬蘇北人民醫院眼科。患者于2018年5月在我院血液科確診為原發于中樞神經系統的彌漫性大B細胞淋巴瘤,經多次化學藥物治療(化療),自訴目前病情穩定。眼部檢查:右眼最佳矯正視力(BCVA)光感,左眼BCVA 1.0。右眼、左眼眼壓分別為22、13 mm Hg(1 mm Hg=0.133 kPa)。右眼角膜清,前房細胞(++),晶狀體輕度混濁,玻璃體混濁明顯;左眼眼前節未見明顯異常。眼底檢查,右眼隱約見后極部及顳側視網膜大片黃白色病灶及出血灶,呈“奶酪番茄醬樣”改變(圖1A);左眼黃斑區黃色環形病灶(圖1B)。光相干斷層掃描(OCT)檢查,左眼黃斑中心凹顳側小片視網膜色素上皮(RPE)隆起(圖1C)。熒光素眼底血管造影(FFA)檢查,右眼視網膜動靜脈管壁均有熒光素著染,周邊視網膜大片無灌注區(圖1D);左眼黃斑區多個點狀強熒光。雙眼房水檢測,右眼巨細胞病毒(CMV)免疫球蛋白(IgG)值86.15 U/ml(參考值范圍<9 U/ml),但CMV、單純皰疹病毒、水痘-帶狀皰疹病毒、EB病毒等病毒核酸拷貝數均為0;雙眼白細胞介素(IL)-10/IL-6比值正常(參考值范圍<1.0)。我院血液科會診認為無其他臟器淋巴瘤復發表現。結合患者病史,眼科診斷:右眼CMV性視網膜炎(CMVR)。因患者病程已有5個月,試予全身靜脈滴注阿昔洛韋、右眼玻璃體腔注射更昔洛韋治療。患者自述右眼疼痛好轉,視力無變化。2個月后再次行右眼房水檢測,提示CMV-IgG濃度為13.61 U/ml,較入院時下降。2020年4月復查,患者右眼視力手動,左眼視力1.0。右眼玻璃體混濁明顯好轉,原病變區視網膜萎縮呈灰色;左眼較前無明顯變化。

2020年10月11日,患者因左眼視力下降4 d于我院復查。右眼BCVA無光感,左眼BCVA 0.6。右眼、左眼眼壓分別為14、12 mm Hg。雙眼玻璃體混濁(+)。眼底檢查,右眼視網膜可見陳舊性病灶(圖2A);左眼鼻下象限視網膜見片狀灰白色病灶,夾雜少量出血灶,顳上及后極部視網膜可見視網膜下呈簇狀分布的點狀白色病灶(圖2B)。眼底自身熒光檢查,左眼后極部視網膜呈“豹斑樣”熒光改變(圖2C);右眼全視網膜散在大量點片狀弱熒光。FFA檢查,左眼鼻下方視網膜血管壁見熒光素滲漏,后極部視網膜呈“豹斑樣”改變(圖2D,2E)。進一步OCT掃描左眼后極部白色點狀病灶處,可見RPE上下多個結節樣強反射病灶(圖2F)。左眼房水檢測,IL-10值顯著升高至248.9 pg/ml(參考值范圍0.0~5.0 pg/ml)、IL-10/IL-6比值升高至3.62,CMV等病毒的核酸拷貝數為0,IgG正常。我院血液科會診行骨髓穿刺、頭顱、腹部CT等檢查后,未發現其他臟器淋巴瘤復發表現。經多科會診,結合患者病史,診斷:原發于中樞神經系統的彌漫性大B細胞淋巴瘤左眼眼內復發,即眼內淋巴瘤(IOL)。血液科認為無需全身化療。遂給予左眼玻璃體腔注射甲氨蝶呤治療,共9次。2021年2月復查,患者全身情況穩定。左眼視力1.0;左眼鼻下及顳上視網膜病灶均明顯消退(圖3A);OCT檢查,左眼后極部視網膜強反射病灶基本消退(圖3B)。2021年9月隨訪,患者病情未復發。

討論 IOL臨床表現變化多端,無特異性。本例患者確診為原發于中樞神經系統的淋巴瘤,因長期化療導致免疫功能低下,右眼眼底表現為典型的“奶酪番茄醬樣”改變,雖然房水檢測僅提示右眼CMV-IgG增高,病毒DNA拷貝數為0,但結合患者的免疫低下狀態,雙眼IL-10/IL-6比值正常,考慮可能為右眼CMVR。經過全身和玻璃體腔抗病毒治療后,患者眼底病灶未進展,病變區視網膜逐步萎縮,復查CMV-IgG濃度降低。1年后再次就診時,患者左眼視力下降,其鼻下方視網膜有出血及黃白色病灶,FFA示左眼血管炎樣改變,結合患者病史,不能排除CMVR可能;但其左眼顳上方視網膜有簇狀分布的白點狀病灶,位于視網膜下,眼底自身熒光及FFA呈“豹斑樣”熒光改變,OCT表現為RPE上下多個結節樣強反射病灶,這些病灶又高度提示淋巴瘤細胞浸潤不除外。研究表明,OCT對IOL的診斷陽性預測值達88.9%[1],RPE層及RPE之上可觀察到增大的結節狀強反射病灶,可有Bruch膜與RPE層分離,形成與息肉樣脈絡膜血管病變類似的雙層征樣改變[2]。于是進一步行左眼房水檢測,提示IL-10/IL-6比值>1,而病毒DNA拷貝數及抗體均不高,結合患者原發性中樞神經系統淋巴瘤病史,考慮患者左眼為IOL浸潤。經左眼連續玻璃體腔注射甲氨蝶呤治療后,患者左眼視力提升,顳上方視網膜下病灶消退,鼻下方類似視網膜血管炎表現的病灶亦消退,驗證了之前的診斷。
IOL可表現為玻璃體混濁及視網膜下浸潤等[3-4],以視網膜血管炎為主要表現的報道并不多見[5]。本例患者左眼有視網膜血管炎表現,但后極部視網膜的黃白色病灶引起了我們的警惕。左眼經玻璃體腔注射甲氨蝶呤治療后病灶均明顯消退,遂考慮為淋巴瘤偽裝成視網膜血管炎而非CMVR。細胞因子分析在IOL的診斷中也存在著重要作用,在該類患者中,IL-10表達量遠超過IL-6,即IL-10/IL-6比值升高并>1[6]。但同時,IOL并不都表現出IL-10或者IL-10/IL-6比值增高,該指標僅可輔助IOL診斷[7]。如果能夠抽取該患者的玻璃體液進行細胞病理學檢查[8-9],對該患者的診斷更有幫助。在本例患者的診斷過程中,我們通過多模式影像學檢查,臨床有了初步擬診,眼內液的檢測起到了重要的輔助作用,為臨床提供了眼內局部抗原和免疫反應信息,有助于快速診斷及精準治療[10]。
56%~90%的原發性IOL患者或將出現中樞神經系統的淋巴瘤表現,而15%~25%的原發性中樞神經系統淋巴瘤患者可發生眼部淋巴瘤表現[11]。根據國際原發性中樞神經系統淋巴瘤協作小組研討會上發布的報告,IOL的診斷可通過腦組織活檢確診淋巴瘤、磁共振成像或腦脊液檢查、眼內組織細胞學或免疫組織化學檢查(IL-10/IL-6輔助)[12]。本例患者有明確的原發性中樞神經系統淋巴瘤病史,因考慮視網膜屬于視覺中樞神經系統起始處,且其他臟器未見淋巴瘤改變,與血液科會診討論,認為該患者第2次就診時左眼的眼部病變為原發于中樞神經系統的彌漫性大B細胞淋巴瘤的眼內復發,而不建議診斷為淋巴瘤眼內轉移。
目前對于IOL的治療,國際上尚無標準統一的治療方案,目前臨床常用的包括全身化療藥物的使用、局部眼球放射治療及玻璃體腔注射甲氨蝶呤[13]。甲氨蝶呤可以穿透血腦屏障及血眼屏障,其治療IOL的有效性及安全性也得到了證實,連續玻璃體腔注射甲氨蝶呤可控制IOL的發展,減少腫瘤復發的可能,甚至提高患者視力[14]。本例患者經血液科評估后,未使用全身化療,單純連續玻璃體腔注射甲氨蝶呤后,病情好轉并且穩定。目前大部分學者認為IOL雖然具有較高的放化療敏感性,但獲得的緩解也僅僅較低的短期總體生存率[15],有效控制該病的遠期復發及中樞神經系統擴散仍然面臨很大挑戰,故本例患者仍需長期隨訪觀察。
淋巴瘤患者的眼部病變變化多端,需要結合臨床表現、眼部多模式影像學檢查、免疫學檢測、細胞學檢查、分子生物學的檢測結果綜合判斷,并建立一個以眼科醫師、神經腫瘤醫師及血液腫瘤學醫師、病理學專家的多學科聯盟,以優化患者的治療方案,改善患者的預后。